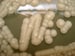
Noncandidal Fungal Infections of the Mouth

Antifungal therapeutic drug monitoring is a critical component of individualized, precision treatment for fungal infections and for antifungal stewardship.[1,2] Antifungal therapeutic drug monitoring is a method to optimize the antifungal treatment regimen for an individual patient by measuring antifungal drug concentrations in a patient's biologic fluids and applying well-described pharmacokinetic principles to adjust the treatment regimen.[3] Measurement of antifungal concentrations is usually performed by analytical assays, such as high-performance liquid chromatography or liquid chromatography-mass spectrometry; bioassays are available for certain azole antifungals (eg, itraconazole). Infectious Diseases Society of America's Guidelines for treatment of fungal diseases like candidiasis, aspergillosis, histoplasmosis, coccidioidomycosis, and blastomycosis recommend therapeutic drug monitoring for certain antifungals, particularly for triazole antifungals (eg, itraconazole, voriconazole, posaconazole)[4,5,6,7,8] Antifungal therapeutic drug monitoring can help improve outcomes through minimizing toxicity associated with supratherapeutic drug levels and prevent treatment failure from subtherapeutic levels.[9,10,11,12] Also, in vitro studies have shown that suboptimal drug levels can lead to antifungal resistance, supporting therapeutic drug monitoring's potential role in preventing the emergence of antifungal-resistant organisms.[13]
Recent studies suggest that antifungal therapeutic drug monitoring is underutilized, leading to missed opportunities to address sub- and supratherapeutic drug levels and improve patient outcomes. An analysis of a hospital discharge data set showed that only 16% of therapeutic drug monitoring–eligible patients receiving itraconazole, posaconazole, or voriconazole had drug level monitoring performed.[14] Among 55 predominately academic medical centers, only 41% of patients receiving isavuconazole, posaconazole, or voriconazole for treatment or prophylaxis of invasive fungal infections had therapeutic drug monitoring performed.[15]
Here are five things to know about antifungal therapeutic drug monitoring to help improve and expand practice in the United States:
1. Clinicians should routinely use therapeutic drug monitoring for patients receiving itraconazole, posaconazole, or voriconazole.
Itraconazole, posaconazole, and voriconazole each have pharmacokinetic variability, drug-drug interactions, and established relationships between drug exposure and response and adverse effects that warrant the use of therapeutic drug monitoring, regardless of the fungal disease.[16] Dosing differs among itraconazole formulations, and several itraconazole formulations have unreliable absorption and slow drug accumulation. Posaconazole's bioavailability varies by type of oral formulation, although newer formulations of this drug may minimize the occurrence of subtherapeutic levels. Voriconazole has substantial intra- and interpharmacokinetic variability leading to sub- and supratherapeutic concentrations and unpredictable outcomes based on dose modifications. Drug-drug interactions are a substantial issue with all of these triazoles and should be carefully assessed because they can affect quality of life through drug adverse effects/toxicities as well as affect therapeutic outcomes. For example, other medications that affect gastric pH can interfere with the absorption of certain azole antifungals; some chemotherapy agents (eg, vincristine), if given concurrently with an azole antifungal, can result in serious toxicity; and combination therapy with anticonvulsants and azole antifungals may necessitate avoiding concurrent use or modification of the anticonvulsant dose.[17]
2. Therapeutic drug monitoring for fluconazole and isavuconazole may improve patient outcomes in specific patient populations.
Therapeutic drug monitoring for fluconazole and isavuconazole is not routinely performed because these antifungals have less pharmacokinetic variability compared with other azole antifungals.[16] However, therapeutic drug monitoring for these drugs may be useful in certain situations. For example, therapeutic drug monitoring for fluconazole may be considered in patients younger than 18 years, in patients in whom there is concern for absorption, and in patients receiving continuous renal replacement therapy. Therapeutic drug monitoring for isavuconazole can be considered in patients receiving alternative methods of administration (eg, administering the content of opened capsules via enteral feeding tubes), with drug-drug interactions, critical illness, extremes of weight, refractory/resistant infections, pediatric, or other factors anticipated to alter pharmacokinetics.
3. The timing of therapeutic drug monitoring for itraconazole, posaconazole, and voriconazole depends on how long it takes to reach steady-state concentration.
Therapeutic drug monitoring for all triazole antifungals should be performed once initial steady state concentration (Table) is reached or if there is a change that may influence steady-state concentration (eg, weight fluctuation, change in dose, condition that may increase or decrease clearance).[16] Itraconazole levels should begin to be monitored approximately 5-7 days after a loading dose is given or 10-14 days without a loading dose; therapeutic drug monitoring can be performed at any point during dosing interval, but troughs may be most common in practice. A posaconazole trough should be drawn after 5 days if a loading dose is given and after 7 days without a loading dose. A voriconazole trough can be collected 2-5 days after a loading dose or after 5 days without a loading dose. As a note, send-out therapeutic drug monitoring tests can often result in longer turnaround times, leading to delays in optimization of the antifungal regimen.
4. The target range for therapeutic drug monitoring concentrations can change on the basis of the triazole antifungal used and whether it is indicated for treatment or prophylaxis.
Target therapeutic drug monitoring concentrations are well established for itraconazole, posaconazole, and voriconazole based on treatment outcomes and toxicity studies (Table).[16] These antifungals also have proposed concentration ceilings to prevent toxicity, although more research is needed to determine levels corelated to specific adverse events. For itraconazole, concentrations ≥ 0.5 mg/L for prophylaxis and ≥ 1 mg/L for treatment are recommended. Although data are somewhat limited regarding the association of adverse events with itraconazole concentrations, some adverse effects may be more frequent at levels > 3-4 mg/L. These levels are based on the itraconazole component only; they do not account for the hydroxy-itraconazole metabolite that is sometimes measured and reported concurrently. For posaconazole, a concentration between ≥ 0.5-0.7 mg/L is recommended for prophylaxis and ≥ 1-1.5 mg/L for treatment. A toxicity ceiling of > 3-3.75 mg/L has been proposed. For voriconazole, a concentration between ≥ 0.5 mg/L for prophylaxis and ≥ 1-2 mg/L for treatment are recommended. Toxicities such as central nervous system effects may be more frequent with levels above 4-5.5 mg/L.
5. Adjusting the dose of triazole antifungals according to therapeutic drug monitoring concentrations can depend on the formulation.
Dose adjustments based on therapeutic drug monitoring results can be made through incremental changes or through newer technologies (eg, Bayesian software).[16] Itraconazole is typically adjusted by different increments on the basis of the formulation: Sporanox: 100-mg increments; Tolsura: 65-mg increments; and the solution 10 mg/mL: 50-100 mg increments. Posaconazole delayed release tablets can be adjusted in 100-mg increments; doses up to 300 mg twice a day have been utilized. Dosing algorithms using Bayesian software have been proposed and implemented to adjust voriconazole doses in some hospital settings; many clinicians still adjust doses in increments of 50-100 mg due to tablet size and its nonlinear pharmacokinetic profile. Of note, therapeutic drug monitoring should also be performed after dose adjustments.
Conclusion
A recent survey found that there are many challenges encountered in performing antifungal therapeutic drug monitoring, including long turnaround times for send-out tests, difficulty coordinating testing logistics, uncertainty around therapeutic drug monitoring recommendations, difficulty interpreting results, uncertainty about therapeutic drug monitoring benefits, cost, and challenges with insurance coverage.[18] Several knowledge gaps about antifungal therapeutic drug monitoring exist including: the use for echinocandins, the role in the outpatient setting, goal therapeutic levels for fungal skin infections, and monitoring for antifungal resistance from subtherapeutic levels.
Antifungal therapeutic drug monitoring can improve outcomes for patients and is a valuable tool for clinicians. Through collaboration among healthcare professionals and laboratorians, utilization of antifungal therapeutic drug monitoring can be optimized in the United States.
Table: Antifungal Therapeutic Drug Monitoring Insights for Itraconazole, Posaconazole, and Voriconazole[16]
| Triazole antifungal |
Indications for therapeutic drug monitoring |
Timing of sample in relation to drug initiation or change in steady-state concentration (adults) |
Target trough concentrations |
Toxicity ceiling for troughs |
| Itraconazole |
Sporanox capsules: all patients, prophylaxis or treatment Suspension or SUBA-itraconazole capsule (Tolsura): consider routinely for treatment Recommended with suspension for prophylaxis |
Any point in the dosing interval; however, troughs are most common in clinical practice Approximately 5-7 days with loading dose, 10-14 days without loading dose |
Prophylaxis: ≥ 0.5 mg/L Treatment: ≥ 1 mg/L (These concentration thresholds are based on the itraconazole component only.) |
3-4 mg/L |
| Posaconazole |
Immediate-release suspension: all patients, prophylaxis or treatment Oral delayed release (DR) tablet, oral DR suspension, or intravenous: consider routine therapeutic drug monitoring for treatment, recommended for prophylaxis |
Trough 5 days with a loading dose, 7 days without a loading dose |
|
> 3-3.75 mg/L |
| Voriconazole |
All patients, prophylaxis or treatment |
Trough, 2-5 days (approximately 2 days with a loading dose, approximately 5 days without loading dose) |
Prophylaxis: ≥0.5 mg/L Treatment: ≥1–2 mg/L |
4-5.5 mg/L |
Follow the CDC on X (formerly known as Twitter)
Follow Medscape on Facebook, X (formerly known as Twitter), Instagram, and YouTube
 5 Things to Know About Antifungal Therapeutic Drug Monitoring
5 Things to Know About Antifungal Therapeutic Drug Monitoring
 The Five Things Dentists Wished PCPs Weren't Missing
The Five Things Dentists Wished PCPs Weren't Missing
 Key Data in Corneal Disorders From AAO 2023
Key Data in Corneal Disorders From AAO 2023
Noncandidal Fungal Infections of the Mouth
Noncandidal Fungal Infections of the Mouth
 Key Data in Corneal Disorders From AAO 2023
Key Data in Corneal Disorders From AAO 2023
 Fungal Infections in Preterm Infants
Fungal Infections in Preterm Infants

COMMENTARY
5 Things to Know About Antifungal Therapeutic Drug Monitoring
Dallas J. Smith, PharmD, MAS; Jeremy A.W. Gold, MD, MS; Kaitlin Benedict, MPH; Nathan P. Wiederhold, PharmD; Melissa D. Johnson, PharmD, MHS
DisclosuresJanuary 03, 2024
Editorial Collaboration
Medscape &
Antifungal therapeutic drug monitoring is a critical component of individualized, precision treatment for fungal infections and for antifungal stewardship.[1,2] Antifungal therapeutic drug monitoring is a method to optimize the antifungal treatment regimen for an individual patient by measuring antifungal drug concentrations in a patient's biologic fluids and applying well-described pharmacokinetic principles to adjust the treatment regimen.[3] Measurement of antifungal concentrations is usually performed by analytical assays, such as high-performance liquid chromatography or liquid chromatography-mass spectrometry; bioassays are available for certain azole antifungals (eg, itraconazole). Infectious Diseases Society of America's Guidelines for treatment of fungal diseases like candidiasis, aspergillosis, histoplasmosis, coccidioidomycosis, and blastomycosis recommend therapeutic drug monitoring for certain antifungals, particularly for triazole antifungals (eg, itraconazole, voriconazole, posaconazole)[4,5,6,7,8] Antifungal therapeutic drug monitoring can help improve outcomes through minimizing toxicity associated with supratherapeutic drug levels and prevent treatment failure from subtherapeutic levels.[9,10,11,12] Also, in vitro studies have shown that suboptimal drug levels can lead to antifungal resistance, supporting therapeutic drug monitoring's potential role in preventing the emergence of antifungal-resistant organisms.[13]
Recent studies suggest that antifungal therapeutic drug monitoring is underutilized, leading to missed opportunities to address sub- and supratherapeutic drug levels and improve patient outcomes. An analysis of a hospital discharge data set showed that only 16% of therapeutic drug monitoring–eligible patients receiving itraconazole, posaconazole, or voriconazole had drug level monitoring performed.[14] Among 55 predominately academic medical centers, only 41% of patients receiving isavuconazole, posaconazole, or voriconazole for treatment or prophylaxis of invasive fungal infections had therapeutic drug monitoring performed.[15]
Here are five things to know about antifungal therapeutic drug monitoring to help improve and expand practice in the United States:
1. Clinicians should routinely use therapeutic drug monitoring for patients receiving itraconazole, posaconazole, or voriconazole.
Itraconazole, posaconazole, and voriconazole each have pharmacokinetic variability, drug-drug interactions, and established relationships between drug exposure and response and adverse effects that warrant the use of therapeutic drug monitoring, regardless of the fungal disease.[16] Dosing differs among itraconazole formulations, and several itraconazole formulations have unreliable absorption and slow drug accumulation. Posaconazole's bioavailability varies by type of oral formulation, although newer formulations of this drug may minimize the occurrence of subtherapeutic levels. Voriconazole has substantial intra- and interpharmacokinetic variability leading to sub- and supratherapeutic concentrations and unpredictable outcomes based on dose modifications. Drug-drug interactions are a substantial issue with all of these triazoles and should be carefully assessed because they can affect quality of life through drug adverse effects/toxicities as well as affect therapeutic outcomes. For example, other medications that affect gastric pH can interfere with the absorption of certain azole antifungals; some chemotherapy agents (eg, vincristine), if given concurrently with an azole antifungal, can result in serious toxicity; and combination therapy with anticonvulsants and azole antifungals may necessitate avoiding concurrent use or modification of the anticonvulsant dose.[17]
2. Therapeutic drug monitoring for fluconazole and isavuconazole may improve patient outcomes in specific patient populations.
Therapeutic drug monitoring for fluconazole and isavuconazole is not routinely performed because these antifungals have less pharmacokinetic variability compared with other azole antifungals.[16] However, therapeutic drug monitoring for these drugs may be useful in certain situations. For example, therapeutic drug monitoring for fluconazole may be considered in patients younger than 18 years, in patients in whom there is concern for absorption, and in patients receiving continuous renal replacement therapy. Therapeutic drug monitoring for isavuconazole can be considered in patients receiving alternative methods of administration (eg, administering the content of opened capsules via enteral feeding tubes), with drug-drug interactions, critical illness, extremes of weight, refractory/resistant infections, pediatric, or other factors anticipated to alter pharmacokinetics.
3. The timing of therapeutic drug monitoring for itraconazole, posaconazole, and voriconazole depends on how long it takes to reach steady-state concentration.
Therapeutic drug monitoring for all triazole antifungals should be performed once initial steady state concentration (Table) is reached or if there is a change that may influence steady-state concentration (eg, weight fluctuation, change in dose, condition that may increase or decrease clearance).[16] Itraconazole levels should begin to be monitored approximately 5-7 days after a loading dose is given or 10-14 days without a loading dose; therapeutic drug monitoring can be performed at any point during dosing interval, but troughs may be most common in practice. A posaconazole trough should be drawn after 5 days if a loading dose is given and after 7 days without a loading dose. A voriconazole trough can be collected 2-5 days after a loading dose or after 5 days without a loading dose. As a note, send-out therapeutic drug monitoring tests can often result in longer turnaround times, leading to delays in optimization of the antifungal regimen.
4. The target range for therapeutic drug monitoring concentrations can change on the basis of the triazole antifungal used and whether it is indicated for treatment or prophylaxis.
Target therapeutic drug monitoring concentrations are well established for itraconazole, posaconazole, and voriconazole based on treatment outcomes and toxicity studies (Table).[16] These antifungals also have proposed concentration ceilings to prevent toxicity, although more research is needed to determine levels corelated to specific adverse events. For itraconazole, concentrations ≥ 0.5 mg/L for prophylaxis and ≥ 1 mg/L for treatment are recommended. Although data are somewhat limited regarding the association of adverse events with itraconazole concentrations, some adverse effects may be more frequent at levels > 3-4 mg/L. These levels are based on the itraconazole component only; they do not account for the hydroxy-itraconazole metabolite that is sometimes measured and reported concurrently. For posaconazole, a concentration between ≥ 0.5-0.7 mg/L is recommended for prophylaxis and ≥ 1-1.5 mg/L for treatment. A toxicity ceiling of > 3-3.75 mg/L has been proposed. For voriconazole, a concentration between ≥ 0.5 mg/L for prophylaxis and ≥ 1-2 mg/L for treatment are recommended. Toxicities such as central nervous system effects may be more frequent with levels above 4-5.5 mg/L.
5. Adjusting the dose of triazole antifungals according to therapeutic drug monitoring concentrations can depend on the formulation.
Dose adjustments based on therapeutic drug monitoring results can be made through incremental changes or through newer technologies (eg, Bayesian software).[16] Itraconazole is typically adjusted by different increments on the basis of the formulation: Sporanox: 100-mg increments; Tolsura: 65-mg increments; and the solution 10 mg/mL: 50-100 mg increments. Posaconazole delayed release tablets can be adjusted in 100-mg increments; doses up to 300 mg twice a day have been utilized. Dosing algorithms using Bayesian software have been proposed and implemented to adjust voriconazole doses in some hospital settings; many clinicians still adjust doses in increments of 50-100 mg due to tablet size and its nonlinear pharmacokinetic profile. Of note, therapeutic drug monitoring should also be performed after dose adjustments.
Conclusion
A recent survey found that there are many challenges encountered in performing antifungal therapeutic drug monitoring, including long turnaround times for send-out tests, difficulty coordinating testing logistics, uncertainty around therapeutic drug monitoring recommendations, difficulty interpreting results, uncertainty about therapeutic drug monitoring benefits, cost, and challenges with insurance coverage.[18] Several knowledge gaps about antifungal therapeutic drug monitoring exist including: the use for echinocandins, the role in the outpatient setting, goal therapeutic levels for fungal skin infections, and monitoring for antifungal resistance from subtherapeutic levels.
Antifungal therapeutic drug monitoring can improve outcomes for patients and is a valuable tool for clinicians. Through collaboration among healthcare professionals and laboratorians, utilization of antifungal therapeutic drug monitoring can be optimized in the United States.
Table: Antifungal Therapeutic Drug Monitoring Insights for Itraconazole, Posaconazole, and Voriconazole[16]
Sporanox capsules: all patients, prophylaxis or treatment
Suspension or SUBA-itraconazole capsule (Tolsura): consider routinely for treatment
Recommended with suspension for prophylaxis
Any point in the dosing interval; however, troughs are most common in clinical practice
Approximately 5-7 days with loading dose, 10-14 days without loading dose
(These concentration thresholds are based on the itraconazole component only.)Prophylaxis: ≥ 0.5 mg/L
Treatment: ≥ 1 mg/L
Immediate-release suspension: all patients, prophylaxis or treatment
Oral delayed release (DR) tablet, oral DR suspension, or intravenous: consider routine therapeutic drug monitoring for treatment, recommended for prophylaxis
Prophylaxis: ≥ 0.5-0.7 mg/L
Treatment: ≥ 1-1.5 mg/L
Prophylaxis: ≥0.5 mg/L
Treatment: ≥1–2 mg/L
Follow the CDC on X (formerly known as Twitter)
Follow Medscape on Facebook, X (formerly known as Twitter), Instagram, and YouTube
Credit:
Lead Image: iStock / Getty Images
Public Information from the CDC and Medscape
Cite this: 5 Things to Know About Antifungal Therapeutic Drug Monitoring - Medscape - Jan 03, 2024.
Tables
References
Authors and Disclosures
Authors and Disclosures
Authors
Dallas J. Smith, PharmD, MAS
Epidemiologist, Mycotic Disease Branch, Centers for Disease Control and Prevention, Atlanta, Georgia
Disclosure: Dallas J. Smith, PharmD, MAS, has disclosed no relevant financial relationships.
Jeremy A.W. Gold, MD, MS
Medical Officer, Mycotic Disease Branch, Centers for Disease Control and Prevention, Atlanta, Georgia
Disclosure: Jeremy A.W. Gold, MD, MS, has disclosed no relevant financial relationships.
Kaitlin Benedict, MPH
Epidemiologist, Mycotic Disease Branch, Centers for Disease Control and Prevention, Atlanta, Georgia
Disclosure: Kaitlin Benedict, MPH, has disclosed no relevant financial relationships.
Nathan P. Wiederhold, PharmD
Director, Fungus Testing Laboratory, Department of Pathology and Laboratory Medicine, University of Texas Health Science Center at San Antonio
Disclosure: Nathan P. Wiederhold, PharmD, has disclosed the following relevant financial relationships:
Received research funding from: bioMerieux; F2G; Mycovia; Scynexis, Inc
Received income from: America Society for Microbiology; British Society of Antimicrobial Chemotherapy
Melissa D. Johnson, PharmD, MHS
Professor in Medicine, Division of Infectious Diseases, Department of Medicine, Duke University Medical Center, Durham, North Carolina
Disclosure: Melissa D. Johnson, PharmD, MHS, has disclosed the following relevant financial relationships:
Received a research grant via her institution from: Scynexis, Inc
Received author royalties from: UptoDate.